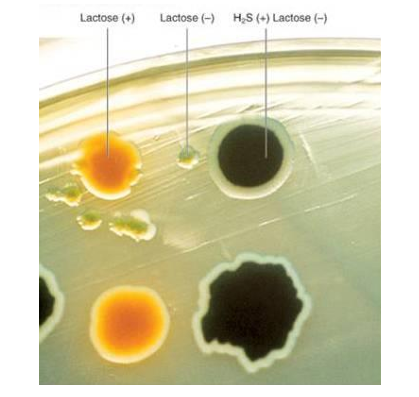

العائلة المعوية Enterobacteriaceae
 المؤلف:
أ.م.د. أسامة ناظم نجرس
المؤلف:
أ.م.د. أسامة ناظم نجرس
 المصدر:
الوجيز في البكتريا الطبية
المصدر:
الوجيز في البكتريا الطبية
 الجزء والصفحة:
ص111-113
الجزء والصفحة:
ص111-113
 2025-02-24
2025-02-24
 697
697
تشمل هذه المجموعة من الكائنات الحية المجهرية العديد من مسببات الاصابات الأولية للقناة المعوية gastrointestinal tract في الانسان، ولهذا السبب يشار اليها على انها معوية enterics (بصرف النظر اذا ما كانت تسبب اضطرابات معوية ام لا).
وافراد هذه العائلة تعتبر المسبب الرئيسي للإصابات الانتهازية opportunistic infection والتي تشمل التسمم الدموي septicemia والالتهاب الرئوي pneumonia والتهاب السحايا meningitis واصابات المسالك البولية urinary tract infections . وكمثال على الاجناس المسببة للإصابات الانتهازية بكتريا Hafnia Escherichia, Enterobacter, Citrobacter, و Serratia Providencia, Morganella,. كما ان من الصعوبة اختيار المضاد الحيوي المناسب نظرا لتنوع هذه الكائنات الحية.
بالإضافة الى ذلك فأن بعض هذه الاجناس تسبب الأمراض المكتسبة من المجتمع (العدوى) في الاشخاص الأصحاء، مثل بكتريا Klebsiella pneumonia التي تشترك في الاصابات التنفسية، والتي تحتوي على محفظة مميزة تساعدها في امراضيتها .كما ان اصابة المسالك البولية (الصاعد ascending) المكتسبة الشائعة تسببها بكتريا E.coli. العائدة لهذه العائلة، وغالبا ما يكون مصدر العدوى (الاصابة) هو التلوث بالبراز. ومن الاجناس الأخرى الشائعة لإصابات المسالك البولية هي بكتريا Proteus، والتي تتميز بظاهرة العج Swarming على الوسط الزرعي الصلب وشبه الصلب وذلك لكونها بكتريا سريعة الحركة، كما تنتج انزيم اليوريز urease الذي يحلل البوريا urea منتجة بول قاعدي.
اما الانواع البكتيرية التي تؤثر على القناة المعوية تشمل سلالات معينة من بكتريا E. coli و Salmonella والانواع الاربعة لبكتريا Shigella كلها وبكتريا Yersinia entercolitica .فمتلازمة رايتر Reiter's syndrome (وهي مرض روماتيزي مرتبط بمعقدات التوافق النسيجي الكبرى نوع HLA-B27 ) يمكن ان تنتج من التعرض المسبق لبكتريا Shigellaو Salmonella و Yersinia ، كما ان هناك انواع بكتيرية غير منتمية للعائلة المعوية مثل Campylobacter و Chlamydia يمكن ان تسبب نفس المتلازمة. ويهتم الباحثون ببكتريا Yersina pestis (المسببة للطاعون plague ) بشكل منفصل لكونها من الانواع البكتيرية المشتركة الاصابة بين الانسان والحيوان .(zoonotic)
عزل وتشخيص العائلة المعوية
خلايا افراد هذه العائلة شكلها عصوية rods موجبة لكرام واختيارية لاهوائية facultative anerobic ،وتفتقر لأنزيم cytochrome oxidase لذا هي تعبر سالبة لفحص انزيم oxidase. وغالبا ما يتم عزلها من البراز على وسط الاكار الحاوي على سكر اللاكتوز lactose وكاشف للدالة الحامضية pH .فالمستعمرات التي تخمر اللاكتوز سوف تنتج كمية كافية من الحامض لتغيير لون الكاشف كما في شكل (1). وتعتبر بكتريا E. coli من مخمرات اللاكتوز في حين ان بكتريا Salmonella, Shigella و Yersinia غير مخمرة له. كما يمكن للسلالات الغير مرضية لبكتريا E.coli (والمعويات الأخرى المخمرة لللاكتوز) ان تظهر في البراز بصورة طبيعية (العائد للشخص الغير مريض). وطالما كان التفريق بين سلالات بكتريا E. coli الممرضة وغير الممرضة صعبا، لذا كانت الانواع الغير مخمرة للاكتوز هي الوحيدة الممكن تشخيصها في البراز على انها ممرضات حقيقية. كما يمكن عزل افراد العائلة المعوية من مواقع اخرى غير البراز مثل البول او الدم والتي يتم تشخيصها بايوكيائيا (على سبيل المثال بأسخدام نظام API 20E). كما يمكن استخدام نظام التنميط المصلي لتفريق بعضها عن بعض باستخدام اضداد نوعية للمستضدات O لمتعدد السكريات الدهني (lipopolysaccharide) وH للأسواط وk للمحفظة.

شكل (1) A-ظاهرة العج Swarming لبكتيريا Proteus على الوسط الصلب B- فحص اليورييز
شكل (2) نمو افراد العائلة المعوية على وسط الماكونكي

شكل (3) نمو افراد العائلة المعوية على وسط اكار الحديد ثلاثي السكريات TSI agar .
 الاكثر قراءة في البكتيريا
الاكثر قراءة في البكتيريا
 اخر الاخبار
اخر الاخبار
اخبار العتبة العباسية المقدسة


